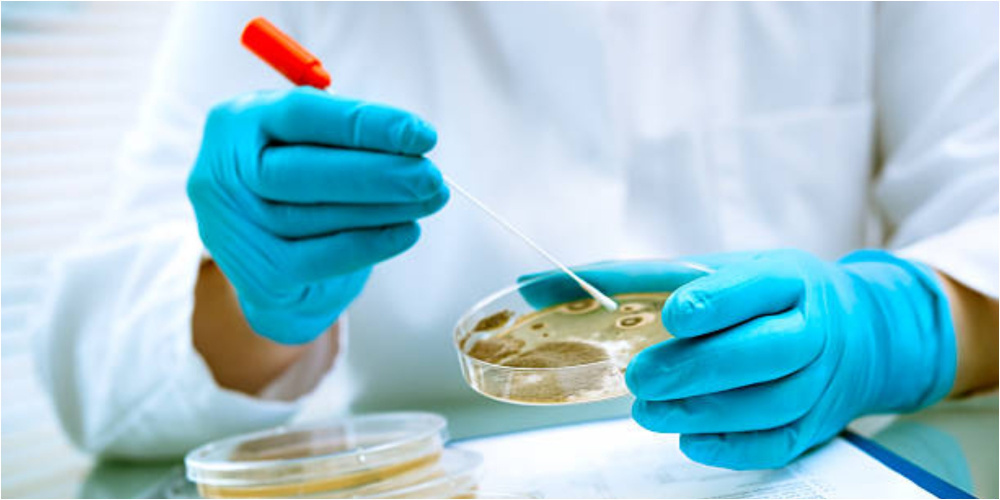

Внутрибольничные инфекции. Исследование показало риски заражения в стационарах Бишкека
В медицинских организациях Бишкека сохраняются риски внутрибольничных инфекций. Основными факторами остаются инвазивные процедуры и длительная госпитализация.
В медицинских организациях Бишкека сохраняются риски внутрибольничных инфекций. Основными факторами остаются инвазивные процедуры и длительная госпитализация.